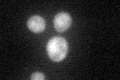
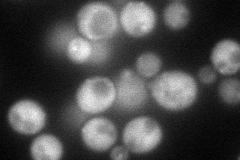
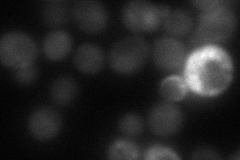
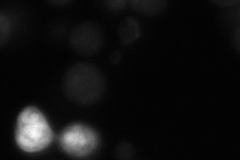
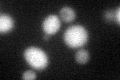

View description
Pbp1p binding protein, interacts strongly with Pab1p-binding protein 1 (Pbp1p) in the yeast two-hybrid system; also interacts with Lsm12p in a copurification assay
Localization:
Intensity:
Fold change:
Significance:
-
C’ GFP library in SD
cytosol44.58 -
N' NOP1pr-GFP in SD
cytosol99.3927 -
N' TEF2pr-mCherry in SD
cytosol24.5614 -
N' NATIVEpr-GFP in SD
cytosol45.2727 -
N' TEF2pr-VC and Cyto-VN in SD

below threshold24.4915 -
C’ GFP library in SD+DTT
cytosol33.110.74No -
C’ GFP library in SD+H2O2

cytosol37.50.84No -
C’ GFP library in Starvation Media

cytosol18.510.41No -
C’ GFP library on the background of Pup2-DaMP

N/A -
C’ GFP library on the background of CCT mutant

N/A0N/AYes
